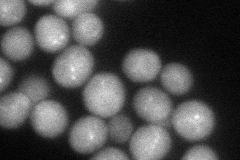
YPR124W
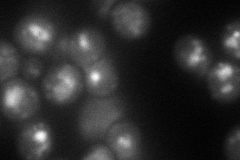
YPR124W
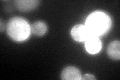
YPR124W
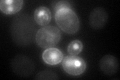
YPR124W

View description
High-affinity copper transporter of the plasma membrane, mediates nearly all copper uptake under low copper conditions; transcriptionally induced at low copper levels and degraded at high copper levels
Localization:
Intensity:
Fold change:
Significance:
-
C’ GFP library in SD

cell periphery26.46 -
N' NOP1pr-GFP in SD
cytosol,punctate75.8737 -
N' TEF2pr-mCherry in SD
punctate,vacuole65.2051 -
N' NATIVEpr-GFP in SD

missing0 -
N' TEF2pr-VC and Cyto-VN in SD

below threshold28.5847 -
C’ GFP library in SD+DTT
cell periphery54.442.05Yes -
C’ GFP library in SD+H2O2

cell periphery38.161.44Yes -
C’ GFP library in Starvation Media

cell periphery23.330.88No -
C’ GFP library on the background of Pup2-DaMP
vacuole, cell periphery -
C’ GFP library on the background of CCT mutant

cell periphery21.86670.826225No
